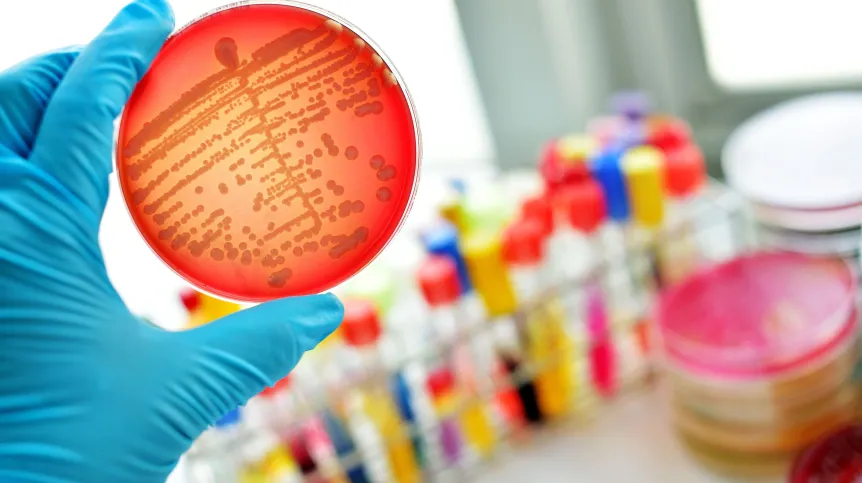
Fot. Adobe Stock

Naukowcy opracowali metodę odfiltrowywania z krwi białka, mającego związek z sepsą. Może ona zwiększyć szanse pacjentów na przeżycie – czytamy na łamach pisma „MedComm”.
Sepsa (posocznica) to zagrażająca życiu, gwałtowna reakcja organizmu na zakażenie, prowadząca do dysfunkcji narządów. Nie jest to choroba, ale zespół objawów wywołanych głównie przez bakterie, rzadziej grzyby lub wirusy.
Sepsa występuje, gdy układ odpornościowy organizmu nadmiernie reaguje na infekcję, uszkadzając tkanki i narządy. Może również dojść do wstrząsu septycznego, kiedy to ciśnienie krwi drastycznie spada, co doprowadza do jeszcze większych uszkodzeń.
Głównymi objawami sepsy są nieprawidłowa temperatura ciała (wysoka gorączka lub zbyt niska temperatura), dreszcze, przyspieszone tętno i oddech, a także dezorientacja.
W roku 2017 na całym świecie odnotowano 49 milionów przypadków sepsy. Jak wykazała późniejsza metaanaliza dotycząca pacjentów z Europy, Ameryki Północnej i Australii, 32 proc. osób z sepsą umiera w ciągu 90 dni, a odsetek ten wzrasta do 39 proc. w przypadku wstrząsu septycznego, nawet jeśli leczona jest pierwotna infekcja i podejmowane są działania, mające kompensować uszkodzenia narządów.
Dr Isaac Eliaz z Amitabha Medical Clinic and Healing Center w Santa Rosa (USA) od dziesięcioleci prowadzi badania nad białkiem zwanym galektyną-3. W organizmach zdrowych osób pełni ono wiele funkcji, na przykład reguluje wzrost, podział i śmierć komórek oraz aktywuje niektóre komórki układu odpornościowego. Białko to ma związek z wieloma chorobami – od autoimmunologicznych po nowotworowe.
Kilka badań wykazało, że wyższy poziom galektyny-3 ma związek z wyższym ryzykiem zgonu u osób z sepsą. Dlatego Eliaz i jego współpracownicy spróbowali odfiltrować to białko z krwi za pomocą specjalnie skonstruowanego urządzenia do pozaustrojowego oczyszczania krwi (aferezy).
Za pomocą wprowadzonego do żyły pacjenta wenflonu pobierana jest pewna objętość krwi. Następnie krew umieszczana jest w wirówce, aby oddzielić komórki od płynnego osocza. Osocze jest przepuszczane przez filtr selektywnie usuwający galektynę-3, dzięki skierowanym przeciwko niej przeciwciałom. Następnie płyn i komórki są znów łączone i przetaczane z powrotem pacjentowi.
Zespół kierowany przez Zhiyonga Penga ze szpitala Zhongnan Uniwersytetu w Wuhan (Chiny) przeprowadził badania 87 osób z sepsą i 27 zdrowych ochotników. Okazało się, że pacjenci z sepsą mieli wyższy poziom galektyny-3. Poziom ten spadł u osób, które przeżyły.
Chiński zespół przetestował także urządzenie do filtracji krwi na dwóch zwierzęcych modelach sepsy. U 48 szczurów sepsa rozwinęła się po nakłuciu części jelita grubego. Krew dwudziestu ośmiu szczurów przefiltrowano pod kątem obecności galektyny-3, a w przypadku pozostałych wykonano pozorowaną aferezę. W grupie poddanej aferezie przeżyło 57 proc, natomiast w kontrolnej - tylko 25 proc.
Aferezę galektyny-3 wypróbowano także na miniaturowych świnkach, którym podano występujący w bakteriach lipopolisacharyd - substancję, która wywołuje silną odpowiedź immunologiczną. Świnki były leczone metodami stosowanymi na oddziale intensywnej terapii, ale u 16 z nich wykonano również aferezę galektyny-3, a 15 – aferezę pozorowaną. I w tym przypadku wskaźnik przeżycia był wyższy w grupie leczonej: 69 proc. w porównaniu z 27 proc.
Wydaje się, że w przyszłości osoby z ciężką sepsą mogłyby być leczone poprzez usuwanie z krwi galektyny-3 - sugerują autorzy badania (DOI: 10.1002/mco2.70659). W przyszłym roku planowane jest przeprowadzenie badania klinicznego na ludziach.
Zanim jednak afereza galektyny-3 będzie mogła stać się standardową praktyką, naukowcy chcą zrozumieć, jaki mechanizm sprawia, że białko to przyczynia się do sepsy. Wyniki powinny zostać powtórzone przez niezależne grupy badawcze, a także na innych zwierzętach, na przykład małpach naczelnych.
Paweł Wernicki (PAP)
pmw/ zan/
Fundacja PAP zezwala na bezpłatny przedruk artykułów z Serwisu Nauka w Polsce pod warunkiem mailowego poinformowania nas raz w miesiącu o fakcie korzystania z serwisu oraz podania źródła artykułu. W portalach i serwisach internetowych prosimy o zamieszczenie podlinkowanego adresu: Źródło: naukawpolsce.pl, a w czasopismach adnotacji: Źródło: Serwis Nauka w Polsce - naukawpolsce.pl. Powyższe zezwolenie nie dotyczy: informacji z kategorii "Świat" oraz wszelkich fotografii i materiałów wideo.

















